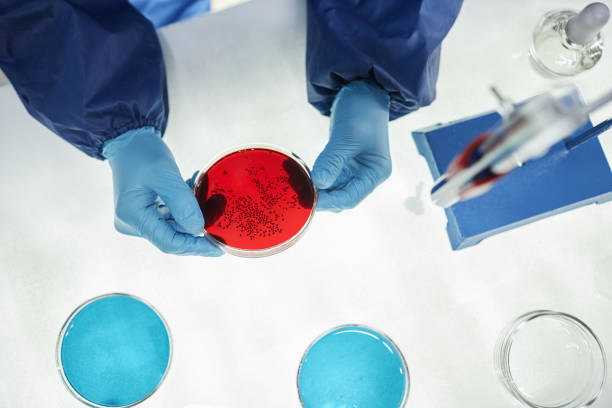

手術恢復是一個緩慢而困難的過程,您需要進行嚴格的物理治療才能完全恢復活動能力。相比之下,干細胞注射有助于“再生”而不是“替代”。干細胞幫助身體自我修復,您的身體更喜歡這種選擇。
干細胞治療比手術更好嗎?
您應該選擇干細胞治療而不是手術的5個理由
疼痛是衰老最令人衰弱的后果之一。每年,數百萬人在美國尋求膝蓋、臀部、肩膀或背部疼痛的治療。相應地,進行的外科手術數量一直在增加,全膝關節和髖關節置換術是最常進行的骨科手術之一。然而,手術真的是理想的解決方案嗎?在邁出這一步之前,您需要了解與手術相關的問題,以及為什么干細胞可能是您更好的選擇。
原因一:手術并不總能消除疼痛
全膝關節置換術通常被認為是緩解膝關節炎疼痛的解決方案。然而,最近的一項審查表明,即使在手術后,仍有20%至40%的患者患有慢性膝關節疼痛!作者甚至認為這個數字可能被低估了,因為許多患者不愿意承認治療可能不起作用。
髖關節置換術后這個數字甚至更高——一項前瞻性研究顯示,多達58%的患者患有以下疾病:髖關節手術后持續疼痛。另一方面,有明確的證據表明干細胞注射可以長期緩解疼痛。
原因2:干細胞治療侵入性較小
不管你喜歡與否,手術本質上是相當野蠻的——患病的關節實際上被切除并用金屬替代品代替。雖然你的大腦知道發生了什么,但你的身體卻感到困惑——為什么我的一部分被切斷了?它問。這個外國“東西”在它的位置上做什么?因此,您的身體及其免疫系統會做出反抗反應。手術后您會立即出現腫脹,腫脹可能嚴重到限制關節的行走和活動。手術恢復是一個緩慢而困難的過程,您需要進行嚴格的物理治療才能完全恢復活動能力。
相比之下,干細胞注射有助于“再生”而不是“替代”。干細胞幫助身體自我修復,您的身體更喜歡這種選擇。它與再生過程配合,并且腫脹最小。研究表明,注射干細胞后短時間內,殘疾評分和運動參數范圍都有很大改善。
原因3:干細胞治療并發癥較少
手術與大量并發癥相關。身體的割傷和切口使其面臨感染的風險。關節本身可能會被感染。這種情況發生在2%的膝關節置換術和高達10%的髖關節置換術中。還存在發生呼吸道感染(例如肺炎)或尿路感染的風險。
由于手術涉及主動切除各種結構,因此總是存在無意中損壞重要血管或神經的風險。大約 2% 的病例會發生神經損傷,輕則導致麻木,重則導致活動減弱。
骨科手術后最嚴重的并發癥是深靜脈血栓(DVT)。發生深靜脈血栓 (DVT) 時,血液會在腿部靜脈內凝結。凝塊可能會脫落并移動到身體的任何地方。如果它到達肺部,它可能會滯留在那里的主要血管中,完全阻止血液流向肺部。這種情況稱為肺栓塞(PE),會導致嚴重胸痛、呼吸困難,甚至死亡。如果不采取預防措施,骨科手術后DVT和PE的發生率高達40%。
相反,干細胞注射不會造成任何DVT風險,也不會導致神經損傷。干細胞感染后發生的感染極為罕見。
手術后需要使用止痛藥,它們會產生一系列副作用和并發癥。手術后您最終會消耗比干細胞治療更多的止痛藥物。干細胞治療最多需要幾周的止痛藥。大多數患者需要的量要少得多。然而,研究表明,接受手術的患者甚至在手術后一年也可能需要服用止痛藥。即使是非處方藥和非麻醉藥物也可能產生長期副作用——胃潰瘍、胃酸過多和長期出血的風險。麻醉藥物會讓你昏昏欲睡,注意力不集中,更不用說你還有對它們產生依賴的風險。
理由4:通過干細胞治療,您可以有多種選擇!
沒有一種治療方法——無論是干細胞療法還是手術——具有100%的治愈率。在某些情況下,治療無效。但如果您接受了手術,您可能實際上就關閉了所有其他治療選擇的大門。再次手術的成功率極低,并且不可能將干細胞注射到已經接受手術的身體部位。相比之下,如果干細胞注射未能給您帶來適當的緩解,您始終可以選擇再次進行干細胞注射。在干細胞注射無法修復關節損傷后,您甚至可以選擇進行手術。因此,理想情況下,在轉向其他治療選擇之前,您應該首先嘗試干細胞療法。
理由五:從長遠來看,干細胞治療更具成本效益
干細胞注射和手術都是相對昂貴的程序。您可能更愿意選擇手術,因為健康保險可以承擔費用。但在你行動之前,請記住保險總是有免賠額的。您的自付費用可能比您想象的要高。此外,手術需要麻醉和麻醉前檢查,這可能會花費您的時間和金錢。手術后恢復時間長也可能導致工資被拖欠。因此,從長遠來看,您可能會發現干細胞注射實際上可能要便宜得多!
考慮到上述幾點,很容易看出為什么選擇干細胞是比手術更好的臨床決策。
參考資料:
Wylde V, Beswick A, Bruce J, Blom A, Howells N, Gooberman-Hill R. Chronic pain after total knee arthroplasty. EFORT Open Rev. 2018 Aug 16;3(8):461-470. doi: 10.1302/2058-5241.3.180004. PMID: 30237904; PMCID: PMC6134884.
Erlenwein J, Müller M, Falla D, et al. Clinical relevance of persistent postoperative pain after total hip replacement – a prospective observational cohort study. J Pain Res. 2017;10:2183–2193. Published 2017 Sep 7. doi:10.2147/JPR.S137892
Orozco L, Munar A, Soler R, Alberca M, Soler F, Huguet M, Sentís J, Sánchez A, García-Sancho J. Treatment of knee osteoarthritis with autologous mesenchymal stem cells: two-year follow-up results. Transplantation. 2014 Jun 15;97(11):e66-8.
Mardones R, Jofré CM, Tobar L, Minguell JJ. Mesenchymal stem cell therapy in the treatment of hip osteoarthritis. J Hip Preserv Surg. 2017 Mar 19;4(2):159-163. doi: 10.1093/jhps/hnx011. PMID: 28630737; PMCID: PMC5467400.
Fuzier R, Serres I, Bourrel R, Palmaro A, Montastruc JL, Lapeyre-Mestre M. Analgesic drug consumption increases after knee arthroplasty: a pharmacoepidemiological study investigating postoperative pain. Pain. 2014 Jul;155(7):1339-1345. doi: 10.1016/j.pain.2014.04.010. Epub 2014 Apr 13. PMID: 24727347.
免責說明:本文僅用于傳播科普知識,分享行業觀點,不構成任何臨床診斷建議!杭吉干細胞所發布的信息不能替代醫生或藥劑師的專業建議。如有版權等疑問,請及時跟本公眾號聯系,我們將在第一時間處理。




 掃碼添加官方微信
掃碼添加官方微信